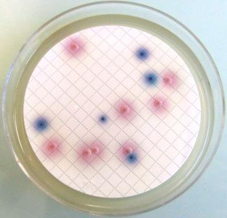
0
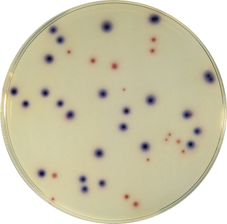
0
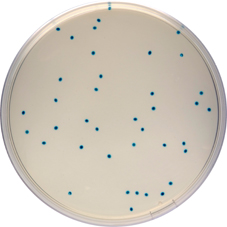
0
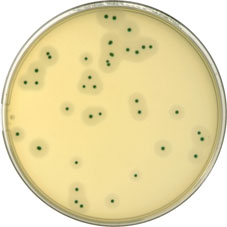
0
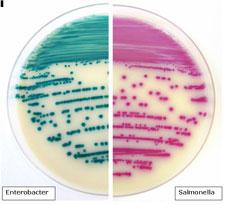
0

Chromogenic Culture Media
Back to category pageChromogenic Media

To facilitate and improve the quality of the microbial testing, we have developed an original range of chromogenic culture media for a wide range of pathogens named Compass available in both prepared and dehydrated formats.
Products Available
 |
Compass Bacillus cereus Agar | Selective isolation | COMPASS Bacillus cereus Agar is a medium used for the detection and enumeration of spores and vegetative forms of Bacillus cereus in food products. Detection or enumeration can be performed directly on this medium without purification steps, biochemical confirmation (glucose fermentation, Voges-Proskauer, nitrate reduction and hemolysis testing) and/or microscopic examination normally done within the confines of standardized methods (notably IDF 181, ISO 7923 and ISO 21871). | Product Sheet |
|
COMPASS CC Agar (BM153) | Selective isolation | Product Sheet | |
|
Compass Ecc Agar | Selective isolation | COMPASS Ecc Agar is a selective chromogenic medium used for the simultaneous and specific enumeration of all Escherichia coli and coliforms in food products and animal feeding stuffs (incubation at 37°C). It can also be used at 44°C to distinguish and enumerate Escherichia coli from other thermotolerant coliforms. | Product Sheet |
|
COMPASS Enterococcus Agar | Selective isolation | COMPASS Enterococcus Agar is a selective media used for the enumeration of enterococci. | Product Sheet |
 |
Compass Salmonella Agar | Selective isolation | COMPASS Salmonella Agar is a selective medium used for the isolation, differentiation and enumeration of all Salmonella. COMPASS Salmonella Agar is also used in the context of the rapid alternative method for the detection of Salmonella (SESAME Salmonella Test), in human and animal food products as well as environmental samples (with the exception of animal production) : it is officially certified by AFAQ AFNOR Certification, under the reference number BKR 23/04-12/07, of which the validity runs until December 4th, 2011. | Product Sheet |
 |
COMPASS Enterobacter sakazakii agar | Selective isolation | COMPASS Enterobacter sakazakii Agar is a selective medium sed for the detection of Enterobacter sakazakii in milk powder, dehydrated products and raw materials often used in infant formulations. | Product Sheet |
|
COMPASS Listeria Agar | Selective isolation | COMPASS Listeria Agar is a selective medium used for the differentiation, isolation and enumeration of Listeria monocytogenes in food products, environmental samples, and animal-based pathological samples regardless of background contamination. | Product Sheet |
|
IRIS Salmonella Agar | Selective isolation | Product Sheet |















